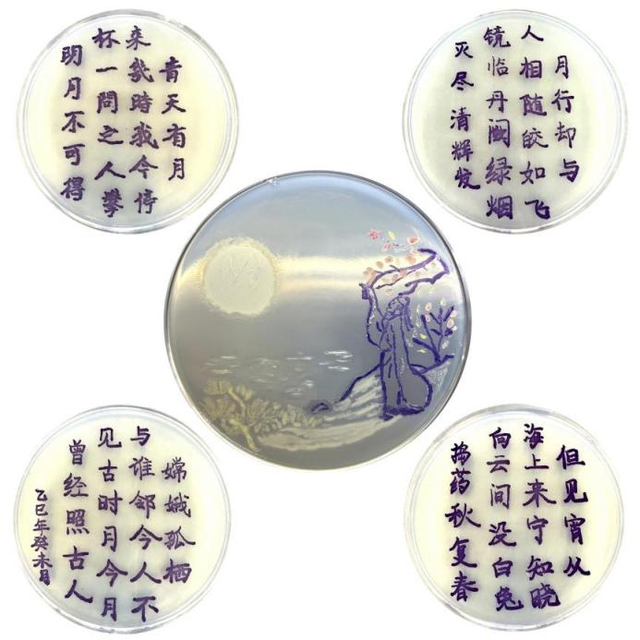

以菌绘万象
一画一乾坤
近日
第四届“习酒杯”全国微生物绘画
艺术大赛落下帷幕

参赛者以培养皿为画布,以接种工具为画笔,以不同微生物为颜料,在方寸之间描绘出科技创新、绿色生态、智能制造等生动精妙的图画,展现出科学与艺术的融合之美!

本届大赛由江南大学承办,国家市场监督管理总局重点实验室(酱香型白酒品质与安全)、贵州省酱香型白酒技术创新中心协办。据悉,本次大赛共计收到优秀参赛作品845幅,经过网络投票、专家评审及线上答辩等环节,共评选出20幅优秀作品。
接下来,让我们一起感受微观世界里
磅礴的生命力与无限创意!
特等奖

作品名称:《锦绣黔承》
作者单位:江南大学
作者:余杨青、顾慧颖、孙驰翔
作品创意:作品灵感来源于国家级非物质文化遗产——苗族刺绣,提炼其最具代表性的构图形式与色彩语言,融合中华传统吉祥文化,通过“福蝶将至”“龙舞呈祥”“年年有余”三幅主题图像,寓意幸福降临、祥瑞呈现与富足安康。整体设计展现了贵州民族艺术的精神图腾,彰显了地域文化与中华美学在当代语境中的创造性转化与创新表达。
一等奖

作品名称:《牡丹佐酒长精神》
作者单位:安庆师范大学
作者:刘晴晴、赵天姿、王鑫
作品创意:牡丹佐酒长精神,微生物绘就奇景。作品借菌落斑斓勾勒牡丹华姿,酒香似隐画间。创意融合自然、艺术与酒文化,以微观之笔绘就宏观盛景,于方寸间展现生命活力与艺术魅力,予人精神滋养。

作品名称:《天地之间》
作者单位:上海交通大学
作者:王赟
作品创意:作品以荧光菌落模拟出星球,将10⁻⁹米的生命结构与10⁹米的天体尺度融为一体。试图诠释“一花一世界”的哲思:多么渺小的局部,都可以全息的方式,映现整个宇宙的全部信息与壮丽图景。

作品名称:《遇酒·悟生》
作者单位:华中农业大学
作者:周佳怡、谭雅君、余靖雯
作品创意:作品围绕古代文人饮酒场景展开,结合人生感悟,以“遇、聚、悟、探”为串联词,从初遇酒与知音的人生兴致,到友人聚饮的情谊沉淀,再借酒悟透山水与内心,最终探问酒中仙意、人生本质,用酒串联起人生不同阶段的感悟与哲思。
二等奖

作品名称:《古法传承-酿酒九序》
作者单位:贵州金沙窖酒酒业有限公司
作者:章德丽、郭小龙、邹宇驰
作品创意:作品以微生物绘画艺术展现传统酿酒九道工艺——润粮、蒸煮、摊凉至储存。古风佳人演绎匠心技艺,将科学笔触与人文美学相融。通过菌绘肌理与古典场景的交织,致敬千年白酒文化,传递「匠心守艺,醇美传世」的东方智慧。

作品名称:《米水之间,点菌成香》
作者单位:南通大学
作者:薛潼、周奕、吴桐
作品创意:作品中她们俯身倾注米与水,微生物在这片温润中悄然生长,以肉眼难见的秩序发酵、转化,唤起香气、滋味与更新,让日常的气息,从微观处缓缓升起。

作品名称:《古酒器焕彩》
作者单位:华中农业大学
作者:魏琪、贺建锟
作品创意:传统酒器曾见证宴饮雅集、礼仪传承,承载千年酒文化记忆。作品将古老酒器以荧光图案呈现,让四羊方尊、青釉提梁倒灌壶、父乙觥、饕餮纹觯等古老酒器在菌皿上重生。旨在用新奇视觉语言,唤醒对传统酒器文化的关注,为非遗文化传承与科学艺术融合提供全新视觉表达,使千年酒器文化借微生物荧光 “重生”,展现独特跨学科艺术魅力。

作品名称:《菌丝织梦,孢子如星》
作者单位:江南大学
作者:张杰、范华林、高惠、潘成双、刘奇
作品创意:黄花遍地,野草随风,田野间隐现村屋的轮廓;巨树横空而立,枝叶交织成天幕,仿佛将观者置于一场被微生物低语环绕的田园黄昏中。
作品名称:《把酒问月》(节选)
作者单位:广西民族师范学院
作者:庞雯雯、卢青青、李广坤
作品创意:作品以微生物生长轨迹勾勒《把酒问月》诗句,让肉眼难见的生命与千年诗魂对话。恰似时光酝酿诗篇的沉淀,菌落晕染的朦胧质感呼应月色清辉,既映现“今月照古人”的时空对话,又以菌落的聚散暗合“月行与人相随”的羁绊。

作品名称:《时光习酒》
作者单位:贵州习酒股份有限公司
作者:谢丹、毕远林
作品创意:作品以微生物为独特创作媒介,将微观生命的奇妙与习酒的时光故事巧妙融合。不同菌群凭借天然的色彩与生长轨迹,在画面中勾勒出酿酒岁月的印记——或许是菌群蔓延如窖池的深邃轮廓,让观者在微观景致中感受到酒与时光、科学与艺术的碰撞,成为一场别开生面的生命美学与品牌文化的对话。
三等奖

作品名称:《醴·觞·酿·匠》
作者单位:南通大学
作者:高冲、谭雨涵、于张炀
作品创意:酒是时间之河,沉浮着文明的倒影。原始火种旁,陶罐初酿是敬畏自然的低语;曲水流觞中,乐舞升腾乃精神交融的微光;作坊氤氲里,汗滴酒糟凝成劳作的颂诗;直至工业洪流中,机械之河无声奔涌。

作品名称:《星垂月涌》
作者单位:天津科技大学
作者:魏薇、周志玥、陆彦蓉
作品创意:繁星入海,月光泄入江河,宛如一条通往光明的道路,一副星辰大海是我们的自由诗。

作品名称:《欢迎光临酿造乐园》
作者单位:江南大学
作者:张坤坤、郭德政、孙澍培、陈晓荣
作品创意:发酵罐化为城堡,CO,气泡成热气球,酒香蒸腾作云朵—微生物精灵在“酿造乐园”中欢腾工作,将粮食魔法般变为琼浆。

作品名称:《山水归心》
作者单位:江南大学
作者:刘书孜怡、张怀志
作品创意:这幅微生物山水画在琼脂平板上以简洁粗犷的方式呈现了传统的中国山水景象,通过微生物的生长展现了自然的和谐与宁静。画面中的山脉、河流与房屋,象征着人类与自然的共生与平衡,而粗糙的线条和模糊的轮廓则让作品带有一种朴素与原始的质感,传递出一种回归自然、寻求内心平静的情感。

作品名称:《灵生肖·运锦程》
作者单位:茅台学院
作者:唐家乐、白云、丁琴
作品创意:以酵母菌绘十二生肖,融微观生命与传统文化。酵母发酵喻转化新生,聚个体成整体显合力。生肖寄吉祥,“运锦程” 寓前程,显自然与艺术共生之妙。

作品名称:《贵妃醉酒》
作者单位:南通大学
作者:周可、章彤、周艺彤
作品创意:用微生物复刻经典,让酒意藏于菌落间,再现古雅醉态与酒文化韵味 。

作品名称:《三曜唐风•诗书剑魂》
作者单位:南通大学
作者:李明、孙柏
作品创意:盛唐风骨,气象万千,尤以李白诗、张旭书、裴旻剑并称“三绝”,尽显磅礴气魄。诗仙太白,醉月孤傲,“兴酣落笔摇五岳”;草圣张旭,笔走龙蛇,“挥毫落纸如云烟”,其书泼墨如雨,癫狂醉态间似有惊雷奔涌;剑圣裴旻,舞若游龙,“剑光寒射惊鸿影”。今欲以淋漓丹青复现其神,三幅联袂,墨色纵横间,追慕那万物皆可入诗、入画、入剑,艺术精神汪洋恣肆的黄金时代。

作品名称:《君子之品》
作者单位:华中农业大学
作者:任可卿、王希亚、郑梓玥
作品创意:作品以君子之品内涵为创作背景:崇道务本的高度与敬商爱人的温度。坚守千年酿酒工艺,执着地追求好酒,是务本;打造传递君品文化,顺天应时中追求进步,是崇道。而敬商则是指尊重商业规律,秉持利他主义,爱人表现为真诚待人,彰显社会责任。

作品名称:《沁园春·雪》
作者单位:山西工学院、江南大学
作者:张佩茹、张亚茹
作品创意:近百年前,一代伟人在经历两万五千里长征、东渡黄河进入山西之际写下了这首气势磅礴的诗句。如今,千千万万个微生物仿照伟人当年的字迹排兵布阵,无声吟唱起“北国风光,千里冰封,万里雪飘。……数风流人物,还看今朝。”

作品名称:《玉虬仪凤齐翔》
作者单位:四川轻化工大学
作者:杜恒吉、赵煜、施宇
作品创意:作品选择链接微生物与传统文化的符号,创造跨时空对话,微生物的繁衍如同文化传承,我们将菌火红的颜色的特征与中国传统文化的龙与凤相融合,体现龙凤呈祥的美好主旨。


一幅幅佳作
是科学的具象
更是艺术创新的表达
在那里
小小的菌落可以是青山绿水
可以是浩瀚星河
它们用自己的生长与色彩
讲述着关于生命、科学与未来的
宏大故事!

本文欢迎微信公众号转载。如需转载,请在文章前注明:本文首发于江南大学,微信号:jnu-1958。
稿件来源:生物工程学院
本期编辑:郭诏金 时丹婷
欢迎您积极投稿或建言献策
投稿邮箱:jndxrmtzx@jiangnan.edu.cn
Copyright © 2014-2024江南大学融媒体中心.